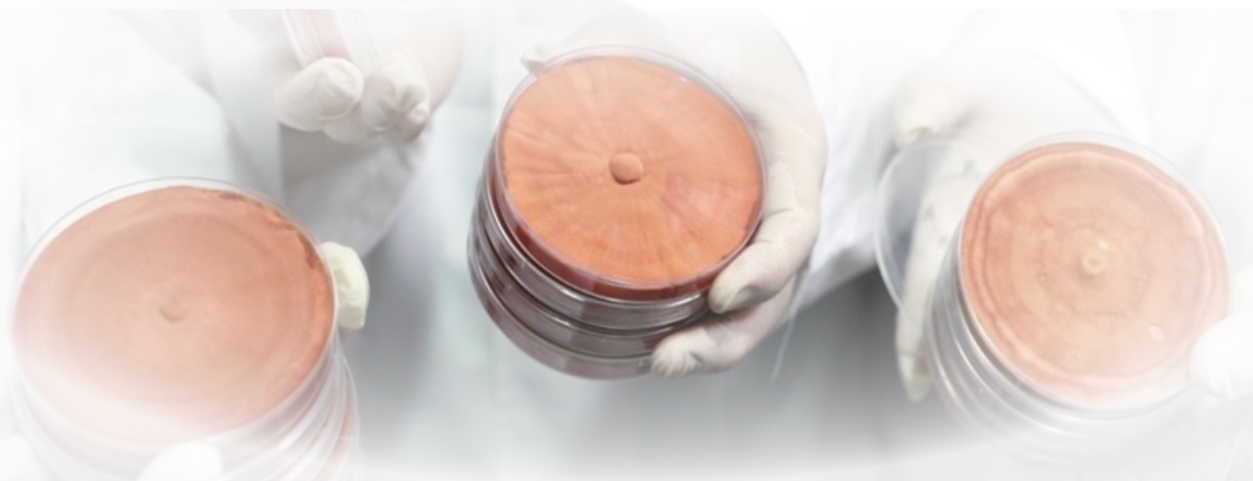

Antrodia camphorata fruiting body capsules

Antrodia camphorata fruiting body capsules

The only edible and medicinal macrofungus native to Taiwan that grows in the world
In 1995, it was published as a new species with the scientific name
Antrodia cinnamomea
It has been confirmed that Antrodia camphorata contains more than 200 kinds of triterpenoids. Its type and content are in the leading position among fungi, ranking first among fungi.
The active ingredients [triterpenes] are dozens of times more powerful than Ganoderma lucidum
Research finds that acute and chronic [liver damage] have significant effects
Experiments have proven that it can quickly affect [cancer cells] in a short period of time
The most amazing health mushroom of this century
The King of Medicinal Mushrooms [Antrodia Antrodia]
Rich in more than 280
Types of triterpene antroic acid
The highest content of triterpenes
crown of fungi
For terminal cancer patients
produce effect
most watched
medicinal fungi
[Antrodia Antrodia fruiting body] has been proven to have a significant effect on terminal cancer patients. The fruiting body has the function of regulating cholesterol, and can induce apoptosis of tumor cells, allowing cancer cells to return to the characteristics of normal cells. This natural Chinese herbal medicine is Taiwan’s unique health mushroom. Its excellent pharmacological functions have attracted widespread attention from the global academic and medical circles.
Pan-cultured Antrodia camphorata fruiting bodies
What is blood-cultured Antrodia amphorata?
This is to cultivate the fruiting body (mushroom body) of Antrodia camphorata with proprietary excellent strains in a sterile room. The harvest is inspected after the growth room. It overcomes the shortcomings of difficulty in obtaining Antrodia camphorata without traditional basswood cultivation, and has less xylem and relatively high quality. Stable and pollution-free. The most attractive thing about blood-cultured Antrodia camphorata is that it has ingredients that are almost the same as those of wild Antrodia camphorata.
Adhere to the preservation environment of clean room-unique cultivation method of Antrodia camphorata
Adhere to the operating environment of clean rooms-Bacteria growing technology in clean rooms

Nano grinding wall breaking
This product is dish-cultured Antrodia camphorata fruiting body powder, which adopts the latest micro-nano cell wall-breaking technology. The introduction of nanotechnology increases the surface area of the substance, and the molecules are small, which is easier for human body to absorb. It is dry ground at low temperature to directly release the raw material ingredients without destroying them, retaining 100% of the active ingredients. The powder is then filled into capsules. Does not contain any chemical additives, completely natural.

Passed the inspection by the international certification inspection unit
The raw materials of the product Antrodia camphorata have passed Taiwan TFDA review and are safe.
The raw materials are pure and the quality meets the standards, so you can feel safe.

Sterile growth with consistent quality
In order to ensure the provision of fruiting bodies of authentic quality and stable activity, the natural culture medium is grown in a sterile growth chamber that simulates near-natural conditions, using high-temperature sterilization technology and strictly monitoring its growth conditions 24 hours a day, including temperature, humidity, Air quality allows the C. camphora to grow smoothly in the best condition.
100% Antrodia camphorata fruiting bodies ground into powder without any added excipients
Combined with science, we use excellent bacterial strains to prepare culture media, high-temperature sterilization technology to ensure zero pollution, stable quality, aseptic inoculation, strict control of sterile growth, and harvesting, drying, and grinding at low temperatures without destroying activity. The production process The medium temperature is maintained at around 30°C, which effectively ensures the high quality of the fruiting bodies of the Cinnamomum angustifolia, ensuring 100% raw material grinding, 100% natural zero added chemicals or other excipients, and scientific instrument-HPLC (liquid phase chromatography) ) Analysis of active ingredients - clearly retaining 100% of the complete activity of the fruiting body of C. cinnamomea, and finally encapsulated by a GMP pharmaceutical factory.
Antrodia camphorata has many benefits and comprehensively improves body protection.
Who is suitable for supplementing Antrodia camphorata?
The efficacy and benefits of Antrodia camphorata have been studied and discussed in relevant empirical medicine literature.
Moderate supplementation of Antrodia camphorata has significant positive effects on the human body, especially on immunity, cancer, liver, etc.
Suitable for those who supplement Antrodia camphorata
- Night owls who stay up late or go to bed late, or those who often drink, socialize, or work overtime
- Hard-working male and female office workers
- Nutritional health supplements and maintenance for senior citizens, senior citizens or vegetarians
- Those who have the three high-risk problems and often eat out and are at high risk of the three high-risk
- Those who are troubled by chronic inflammation and need anti-inflammation
Thoughtful little reminder
1. Not suitable for pregnant women and breastfeeding women
2. Patients who are being treated for diseases or taking specific drugs (please consult a professional doctor for advice)
3. Menstrual period (recommended to evaluate consumption)
4. In the state two weeks before and after surgery
5. Too young toddlers/children/infants
Antrodia camphorata has a long history of consumption and is a very safe health food with no special
Taboo, as long as you follow the eating instructions and eat in moderation.

